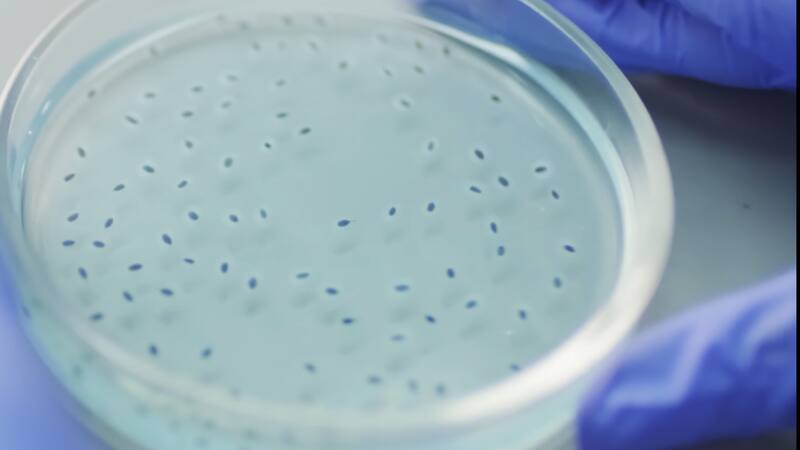

Investigadores buscan presencia de coronavirus en Animales silvestres
Luego de un brote de COVID-19 ocurrido en 2020 en la base O'Higgins, un grupo de investigadores volverá al lugar para ver si es posible confirmar la presencia de este virus.
COMENTARIOS
Para comentar este artículo debes ser suscriptor.











